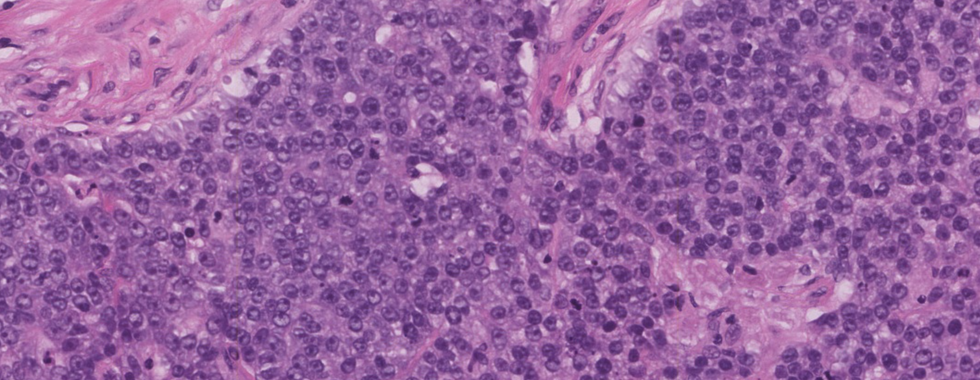

Case 1: Breast lump, BIRADS V
- Feb 12
- 11 min read
scroll down to see the diagnosis
Diagnosis: Invasive ductal carcinoma (NOS), grade 3 with a focus of DCIS
High yield facts on Malignant epithelial tumors of the breast
Clinical features
The most commonly diagnosed malignant tumor of the breast
Epithelial carcinomas arise from the epithelial part of the breast
The epithelial part composed of the cells that lined the lobules and terminal ducts
Most commonly seen in 40 to 60 years of age
Presents as a mass or nipple discharge that can be sanguineous (bloody), serous, mucinous, and milky, or purulent
In some cases, skin ulceration, dimpling (peau d’orange), and nipple retraction can be seen
On physical examination of occult breast cancer, the mass is usually impalpable, with axillary lymphadenectasis as the first symptom
Common risk factors are a positive family history of breast carcinoma, early menstruation, late menopause, and nulliparity
Some patients present as palpable or mammographically suspicious calcifications
Prognosis depends on many factors; the most important is lymph node status
Gross pathology
Histopathological diagnosis is the basis of the confirmative diagnosis and planning of treatment of breast cancer.
Tissue samples like core biopsy, lumpectomy, excision biopsy, and mastectomy specimen received for the diagnosis of malignant epithelial neoplasm of breast.
The intra-operative specimens can be submitted for frozen section examination and then submitted for histopathological examination.
● Or, a pathologist finds at least 10 or more lymph nodes in the specimen, and all shall be sampled.
● To retain the anatomy of the specimen, dissect along the connecting line between the nipple and tumor center/incisal opening/scar, and ensure the bottom of the specimen is connected.
● If the specimen is too large, make several sections parallel to the first incision.
● After removing blood, wipe the specimen dry, then keep the specimen fixed 24-48 hours for sampling.
● After fixation, multiple sections were dissected along the direction parallel to the incisal opening that is made on the first day and then observe and record the findings.
Gross examination findings of the different type of breast cancers
● IDC NOS: The mass is firm to hard, fibrotic typically with stellate, infiltrative borders.
● ILC: In this type of tumor size varies from microscopic to well-defined, large masses present throughout the breast). In some cases, form a hard mass with irregular, infiltrative margins
● Medullary carcinoma: Tumors that are typically well-circumscribed, noninvasive; often show distinct capsules. Faintly nodular, soft, tan-brown, or gray tumor with brain-like consistency.
● Mucinous carcinoma: Well-circumscribed, forming a gelatinous mass
● Tubular carcinoma: Mostly size is less than 2 cm in diameter, firm, stellate, having the sclerotic appearance
● Metaplastic carcinoma: Distinct, firm mass with defined margins, nodular, or cystic areas can be present.
● Secretory carcinoma: Well-defined, circumscribed, nodular mass. Cut surface shows gray-white or tan tumor
● Inflammatory carcinoma: Skin is erythematous and thickened. Mostly associated with an invasive breast carcinoma
● Sections submitted for examination - Tumor proper, Tumor edge, Tumor with the nearest margin, sections from areas of DCIS suspicion, normal breast near to the tumor, nipple, and areola, margins (superior, inferior, medial, lateral, deep surgical margins), lymph nodes.
Microscopic features
2019 WHO classification of tumors of the breast: Epithelial tumors (Malignant);
Invasive breast carcinoma
● Infiltrating duct carcinoma (IDC) NOS,
● Oncocytic carcinoma,
● Lipid rich carcinoma,
● Glycogen rich carcinoma,
● Sebaceous carcinoma,
● Lobular carcinoma
● Tubular carcinoma,
● Cribriform carcinoma
● Mucinous adenocarcinoma,
● Mucinous cystadenocarcinoma NOS,
● Invasive micropapillary carcinoma of the breast,
● Metaplastic carcinoma NOS,
Rare and salivary gland type tumors
● Secretory carcinoma,
● Acinar cell carcinoma,
● Mucoepidermoid carcinoma,
● Polymorphous adenocarcinoma,
● Adenoid cystic carcinoma,
● Classic adenoid cystic carcinoma
● Solid basaloid adenoid cystic carcinoma
● Adenoid cystic carcinoma with high-grade transformation
● Tall cell carcinoma with reversed polarity,
Infiltrating duct carcinoma NOS
● The most common subtype of invasive breast carcinoma, comprising 70% to 75%.
● The growth pattern of this tumor is heterogenous that can be solid, trabecular, in cords, in tubules, or as single cells
● The tumor cells show moderate to marked pleomorphism.
● Abundant and eosinophilic cytoplasm. Nuclei may be highly pleomorphic, or regular with prominent nucleoli and glandular pattern may be extensive or absent.
● A highly cellular desmoplastic stromal fibroblastic proliferation, a scanty connective tissue element, or marked hyalinization may be seen.
● Focal necrosis may be present (seen in approximately 60% of cases)
● The prominent lymphoplasmacytic response was seen in 15% to 20% of cases.
● In the high-grade tumor, angiolymphatic or perineural invasion often seen
Lobular carcinoma
● Histologic variants seen:
● Classic. Comprises approximately 40% of infiltrating lobular carcinomas
● Tumor cells are seen in a linear or single-file (Indian filing) pattern in a sclerotic background
● Cells may show mucin-filled vacuoles sometimes resulting in signet ring cells.
● The tumor cells are relatively uniform and have round to ovoid irregular nuclei with inconspicuous nucleoli and a thin rim of cytoplasm.
● The nuclei are often eccentrically placed and exhibit little pleomorphism, and mitoses are less common.
● It is rarely associated with a lymphomonocytic reaction or granulomatous inflammation.
● Alveolar. 4% to 5% of lobular carcinomas.
● Numerous small round clusters of tumor cells separated by fibrous stromal tissue
● Solid. Approximately 10% of lobular carcinomas.
● Typical lobular cells, but they arranged in sheets rather than single cords, with less amount of stroma
● The cells are more pleomorphic and have more frequent mitoses than in the classic type.
● Tubulolobular. A rare variant, small tubule formation with linear infiltration is seen.
● Pleomorphic. Having classic lobular infiltrative pattern but with cells exhibiting cellular atypia, particularly nuclear pleomorphism,
● Has high-grade nuclei and high mitotic index
Tubular Carcinoma
● Classically seen as open tubules, consisting of a single layer of epithelial cells enclosing a clear lumen.
● These tubules are generally oval or rounded and angulated and haphazardly arranged.
● Bland cytologic features, including cells with small nuclei and eosinophilic cytoplasm; rare mitotic activity.
● Tubules lack myoepithelial cells
● Pure tubular carcinoma must have 100% tubular architecture.
● DCIS is associated with up to 40% of cases; 10% are associated with LCIS.
Mucinous Carcinoma
● Also known as mucoid, colloid, or gelatinous carcinoma.
● The tumors consist of small islands or clusters of uniform, round epithelial cells (10-20 cells) set within extensive lakes of extracellular mucin
● The term mucinous carcinoma can only be applied to tumors having at least 90% of pure mucinous structure.
Medullary Carcinoma
Three main morphologic criteria:
The epithelial cells are arranged in interconnecting sheets and syncytial pattern. The cells are large pleomorphic with abundant cytoplasm and vesicular nuclei containing one or more nucleoli and showing a proportion of bizarre nuclei and a high mitotic count, that is, histologic grade 3. This pattern should comprise at least 75% of the tumor area. Glandular or tubular structures are not seen.
The intervening stroma is less and contains a moderate to severe lymphoplasmacytic infiltrate that does not intervene extensively between individual tumor cells.
The border of the tumor is pushing rather than infiltrative.
Invasive Papillary Carcinoma
● The classical feature is papillary structures with fibrovascular cores.
● Papillae must be with the absence of myoepithelial cell layer
● Diagnosis of invasive papillary carcinoma should be made only with the identification of unequivocal stromal invasion, which in some places breaches the capsule.
Metaplastic Carcinoma
● The heterogeneous group characterized by an admixture of malignant epithelial elements (adenocarcinoma) with malignant “mesenchymal” elements including cartilage, bone, and myxoid stroma, and/or squamous or spindle cell elements
Staging and grading
Histologic Grade (Nottingham Histologic Score)
● No residual invasive carcinoma
Glandular (Acinar)/Tubular Differentiation
● Score 1 (>75% of tumor area forming glandular/tubular structures)
● Score 2 (10% to 75% of tumor area forming glandular/tubular structures)
● Score 3 (<10% of tumor area forming glandular/tubular structures)
● Only micro invasion present (not graded)
● No residual invasive carcinoma
● The score cannot be determined
Nuclear Pleomorphism
● Score 1 (nuclei small with little increase in size in comparison with normal breast epithelial cells, regular outlines, uniform nuclear chromatin, little variation in size)
● Score 2 (cells larger than normal with open vesicular nuclei, visible nucleoli, and moderate variability in both size and shape)
● Score 3 (vesicular nuclei, often with prominent nucleoli, exhibiting marked variation in size and shape, occasionally with very large and bizarre forms)
● Only micro invasion present (not graded)
● No residual invasive carcinoma
● A score cannot be determined
Mitotic rate (see Table)
● Score 1
● Score 2
● Score 3
● Only micro invasion present (not graded)
● No residual invasive carcinoma
● A score cannot be determined
Overall Grade
● Grade 1 (scores of 3, 4, or 5)
● Grade 2 (scores of 6 or 7)
● Grade 3 (scores of 8 or 9)
Scoring Categories of Mitotic Counts
Field diameter (mm)
Area (mm2)
Number of mitoses per 10 fields corresponding to:
Score 1
Score 2
Score 3
0.40
0.125
≤4
5 to 9
≥10
0.41
0.132
≤4
5 to 9
≥10
Pathologic Stage Classification (pTNM, AJCC 8th Edition) (Note M)
Primary Tumor (pT)
● pTX: Primary tumor cannot be assessed
● pT0: No evidence of primary tumor#
● pTis (DCIS): Ductal carcinoma in situ#
● pTis (Paget): Paget disease of the nipple not associated with invasive carcinoma and/or DCIS in the underlying breast parenchyma##
● pT1: Tumor ≤20 mm in greatest dimension
● pT1mi: Tumor ≤1 mm in greatest dimension
● pT1a: Tumor >1 mm but ≤5 mm in greatest dimension (round any measurement >1.0−1.9 mm to 2 mm)
● pT1b: Tumor >5 mm but ≤10 mm in greatest dimension
● pT1c: Tumor >10 mm but ≤20 mm in greatest dimension
● pT2: Tumor >20 mm but ≤50 mm in greatest dimension
● pT3: Tumor >50 mm in greatest dimension
● pT4: Tumor of any size with direct extension to the chest wall and/or to the skin (ulceration or skin nodules) ###
● pT4a: Extension to the chest wall; invasion or adherence to pectoralis muscle in the absence of invasion of chest wall structures does not qualify as T4
● pT4b: Ulceration and/or ipsilateral macroscopic satellite nodules and/or edema (including peau d’orange) of the skin that does not meet the criteria for inflammatory carcinoma
● pT4c: Both T4a and T4b are present
● pT4d: Inflammatory carcinoma
Regional Lymph Nodes (pN)
● pNX: Regional lymph nodes cannot be assessed (eg, not removed for pathological study or previously removed)
● pN0: No regional lymph node metastasis identified or ITCs only#
● pN0 (i+): ITCs only (malignant cell clusters no larger than 0.2 mm) in regional lymph node(s)
● pN0 (mol+): Positive molecular findings by reverse transcriptase-polymerase chain reaction (RT-PCR); no ITCs detected
● pN1mi: Micrometastases (approximately 200 cells, larger than 0.2 mm, but none larger than 2.0 mm)
● pN1a: Metastases in 1 to 3 axillary lymph nodes, at least 1 metastasis larger than 2.0 mm
● pN1b: Metastases in ipsilateral internal mammary sentinel nodes, excluding ITCs
● pN1c: pN1a and pN1b combined
● pN2a: Metastases in 4 to 9 axillary lymph nodes (at least 1 tumor deposit larger than 2.0 mm)##
● pN2b: Metastases in clinically detected internal mammary lymph nodes with or without microscopic confirmation; with pathologically negative axillary nodes
● pN3a: Metastases in 10 or more axillary lymph nodes (at least 1 tumor deposit larger than 2.0 mm) or metastases to the infraclavicular (Level III axillary lymph) nodes
● pN3b: pN1a or pN2a in the presence of cN2b (positive internal mammary nodes by imaging); or pN2a in the presence of pN1b
● pN3c: Metastases in ipsilateral supraclavicular lymph nodes
Distant Metastasis (pM)
● pM1: Histologically proven metastases larger than 0.2 mm
Special Stains and Immunohistochemistry
Infiltrating duct carcinoma NOS,
● ER and PgR are positive in all cases of well and moderately differentiated tumors
● In high grade, PgR is negative and ER and HER-2-neu are positive.
● Other IHC markers eg: CK8/18, CK19, EMA, and E-cadherin shows positivity
● The proliferative marker (Mib-1/Ki67) shows more intensity in higher grades.
Lobular carcinoma
● Special stains like mucicarmine, alcian blue, and PAS are positive for intracytoplasmic mucin.
● Proliferative marker (Mib-1/Ki67) and ER/PgR shows variable positivity
● HER-2-neu: positive in 30 % of cases
● GCDFP 15 shows positivity in some cases
Tubular Carcinoma
● Only ER shows positivity, PgR, HER-2-neu, and EGFR are negative
Mucinous Carcinoma
● Special stains like PAS are positive for intracytoplasmic mucin.
● Cytokeratin 7 -positive, ER/PgR - variable positivity, HER-2-neu - negative
Medullary Carcinoma
● ER/PgR- Negative in 90% cases, Cytokeratin ⅚, p53, Mib-1 - Positive and HER-2-neu - negative
Invasive Papillary Carcinoma
● ER/PgR- Positive, HER-2-neu - negative
● CEA is positive in 80-90% of cases.
Metaplastic Carcinoma
● The epithelial component of the tumor is positive for cytokeratin AE1/3, CK5/6, 15, and EMA.
● Vimentin is positive in both mesenchymal and epithelial components of the tumor.
*FOXA1 is an excellent breast carcinoma marker, but it is positive in triple-negative carcinomas
Molecular pathology
● Based on gene expression analysis, four different molecular types of breast carcinoma were described: luminal A, luminal B, basal-like, and c-erbB-2(HER-2-neu) positive.
● Other molecular subtypes are identified in recent years: cloudin low, interferon rich, and molecular apocrine.
Luminal A tumors
● 50% of invasive breast cancers
● Mainly low- to intermediate-grade, estrogen receptor-positive,
● Most tumors are c-erbB-2- negative tumors with low proliferation.
● Examples, including classic lobular, tubular, and mucinous carcinomas.
Luminal B tumors
● 20 % of invasive breast cancers
● Mainly intermediate- to high-grade, ER-positive tumors with a high proliferation rate;
● HER-2-neu expression is variable
HER-2-neu (c-erbB-2)-positive tumors
● 15 % of all invasive breast cancers
● High-grade carcinomas, mostly HER-2-neu (c-erbB-2)-positive
● Usually negative for estrogen and progesterone receptors,
● Ki-67 expression is high, and TP53 mutation is common.
● Most tumors have lymph node metastasis and poor prognosis.
Basal-like carcinomas
● 15% of all invasive carcinomas.
● Triple-negative carcinomas; typically high-grade tumors with high proliferation rates.
● Basal epithelial markers: cytokeratins 5/6, 14, and 17 - positive.
● Subtypes of these tumors also show mesenchymal differentiation and positivity for vimentin.
Differential diagnosis
● Malignant tumors such as other types of invasive breast cancers, metastatic carcinomas, non-invasive carcinomas, and
● Benign lesions such as sclerosing adenosis and radial scar.
● Radial scar shows the central zone of fibrosis and elastosis with a stellate or radial arrangement of ductules. No infiltration into adjacent adipose tissue. Proliferating ducts show myoepithelial cells.
● Sclerosing adenosis shows Benign ductal proliferation that retains lobular architecture. Lacks infiltration into surrounding adipose tissue. Ductules show a myoepithelial cell layer
Prognosis
Prognosis depends on:
● Patient age,
● Tumor type: Prognosis according to histological type (10-year survival): Poor prognosis (<50%)- IDC, mixed IDC & ILC, solid and pleomorphic lobular, and metaplastic type. Intermediate prognosis (50-60%) - Classical lobular, medullary, and invasive papillary. Good prognosis (60-80%) - Tubular mixed, alveolar lobular, mixed ductal. Excellent prognosis (>80%): Tubular, cribriform, mucinous, tubulolobular, and encysted papillary.
● Tumor size,
● Tumor grade,
● Lymphovascular invasion,
● Lymph node involvement ()and
● Hormonal status. ER-negative, lymph node-positive, and HER2 positive cancers confer higher risk.
How to sign out the case
● Procedure: Excision (less than total mastectomy)/ Total mastectomy (including nipple-sparing and skin-sparing mastectomy)
● Specimen Laterality: Right/ Left/ Not specified
● Tumor Site: Upper outer quadrant/ Lower outer quadrant/ Upper inner quadrant/ Lower inner quadrant/ Central/ Nipple
● Tumor Size: ___x___x___cm.
● Histologic Type:
○ No residual invasive carcinoma
○ Invasive carcinoma of no special type (ductal)
○ Micro-invasive carcinoma
○ Invasive lobular carcinoma
○ Invasive carcinoma with mixed ductal and lobular features
○ Invasive carcinoma with features of (specify): _______________________
○ Tubular carcinoma
○ Invasive cribriform carcinoma
○ Mucinous carcinoma
○ Invasive micropapillary carcinoma
○ Apocrine adenocarcinoma
○ Metaplastic carcinoma
○ Encapsulated papillary carcinoma with invasion
○ Solid papillary carcinoma with invasion
○ Intraductal papillary adenocarcinoma with invasion
○ Adenoid cystic carcinoma
○ Neuroendocrine tumor
○ Neuroendocrine carcinoma
○ Invasive carcinoma, a type cannot be determined
○ Other histologic type (specify): _________________
○ Histologic Grade (Nottingham Histologic Score):
● Tumor Focality: Single focus of invasive carcinoma/ Multiple foci of invasive carcinoma
● Ductal Carcinoma In Situ (DCIS): Not identified/ Present
○ Architectural Patterns: Comedo/ Cribriform/ Micropapillary/ Papillary/ Solid/ Paget disease (DCIS involving nipple skin)
● Lobular Carcinoma In Situ (LCIS): Not identified/ Present
● Tumor Extension: Skin/ Nipple/ Skeletal Muscle
● Margins(Anterior/ Posterior/ Superior/ Inferior/ Medial/ Lateral): Cannot be assessed/ Uninvolved by invasive carcinoma/ Involved by invasive carcinoma
● Regional Lymph Nodes (Number or Size): No lymph nodes submitted or found/ Uninvolved by tumor cells/ Involved by tumor cells
● Extranodal Extension: Not identified/ Present
● Treatment Effect in the Breast: No/ Yes known presurgical therapy.
● Lymphovascular Invasion: Not identified/ Present
● Pathologic Stage Classification (pTNM, AJCC 8th Edition):
● Ancillary Studies: (Estrogen Receptor or Progesterone Receptor or HER2 (by immunohistochemistry/ by in situ hybridization): Positive/ Low positive/ Negative.
● Microcalcifications: Not identified/ Present in DCIS or Invasive carcinoma or non-neoplastic tissue.
References
● Westra W. Surgical Pathology Dissection. 2nd ed. New-York: Springer-Verlag; 2003.
● Rosai J, Ackerman L, Goldblum J, Lamps L, McKenney J, Myers J. Rosai And Ackerman's Surgical Pathology. 11th ed. Philadelphia: Elsevier; 2018.
● Mills S, Sternberg S. Sternberg's Diagnostic Surgical Pathology. 5th ed. Philadelphia, PA: Lippincott Williams et Wilkins; 2015.
● Gattuso P, Reddy V, David O, Spitz D, Haber M. Differential Diagnosis In Surgical Pathology. 3rd ed. London: Elsevier Health Sciences; 2015.
● Lakhani S. WHO Classification Of Tumours Of The Breast. Lyon: International Agency for Research on Cancer; 2014.
● Cancer Protocol Templates. College of American Pathologists. https://www.cap.org/protocols-and-guidelines/cancer-reporting-tools/cancer-protocol-templates. Published 2020. Accessed October 25, 2020.

Comments